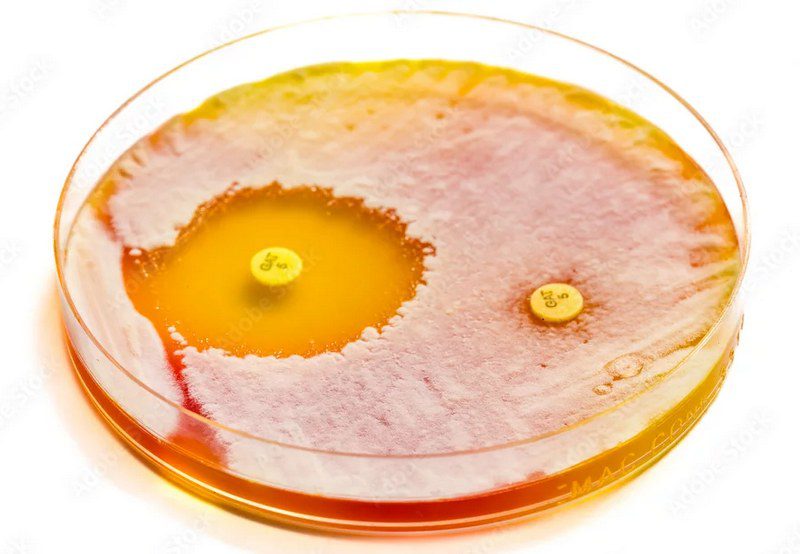

مقاومت ضدمیکروبی (AMR) یا مقاومت دارویی وضعیتی است که در آن میکروارگانیسمها به داروها پاسخ نمیدهند و اثربخشی درمان کاهش مییابد. این پدیده میتواند ناشی از جهش ژنتیکی، انتقال ژنهای مقاومت، استفاده نادرست از داروها در انسان و حیوان، و آلوده شدن محیط باشد. علائم مقاومت شامل عدم بهبود یا بدتر شدن وضعیت بیمار طی درمان مناسب است، و شناسایی سریع آن برای مدیریت بیماری حیاتی است. در دامپزشکی، حیوانات میتوانند مخزن میکروبهای مقاوم باشند و مصرف آنتیبیوتیکها برای پیشگیری یا رشد میتواند مقاومت را گسترش دهد. پیامدها در دام شامل کاهش رفاه، افزایش مرگومیر و انتقال به انسانهاست. در پزشکی، AMR باعث کاهش گزینههای درمان، طولانی شدن مدت بستری، افزایش مرگومیر، پیچیدهتر شدن پروتکلهای درمانی و دشواری پیشگیری و کنترل عفونتها میشود. مدیریت هوشمند داروها و نظارت دقیق ضروری است.

مقاومت دارویی یعنی چه؟
مقاومت دارویی یا AMR — عبارتی که معمولاً به کاهش اثربخشی دارویی گفته میشود — یکی از مهمترین چالشهای دامپزشکی و پزشکی امروز است. بهزبان ساده، وقتی دارویی که قبلاً بیماری را کنترل میکرد، دیگر اثرگذاری لازم را ندارد، میگوییم مقاومت دارویی به وجود آمده است. به طور دقیقتر، این پدیده زمانی رخ میدهد که میکروارگانیسمها (باکتریها، ویروسها، قارچها یا انگلها) یا گاهی سلولهای سرطانی، نسبت به دارویی که پیشتر آنها را مهار یا نابود میکرد، حساسیتشان را از دست بدهند یا مکانیسمهایی برای مقابله با آن دارو بیابند.
چرا مقاومت دارویی اهمیت دارد؟
کاربرد نادرست یا بیش از حدِ داروها در انسان، استفاده پیشگیرانه یا رشددهنده در دام و کاربرد ناکافیِ تشخیصهای دقیق، فشار انتخابی قوی ایجاد میکند؛ میکروبهای مقاوم زنده مانده و مقاومت را گسترش میدهند. همینطور آلوده شدن محیط (آب و خاک) به بقایای دارویی میتواند خطر را تشدید کند. وقتی دارویی نتواند بیماری یا عفونت را بهخوبی مهار کند، پیامدهایش میتواند خطرناک باشد: دوره بیماری طولانیتر میشود، احتمال بروز عوارض بیشتر است، هزینههای درمان افزون میشود و گزینههای درمان کاهش مییابند. با توجه به اهمیت این موضوع مرکز کنترل و پیشگیری سازمان بهداشت عمومی ایالات متحده آمریکا Centers for Disease Control and Prevention (CDC) اعلام کرده که مقاومت دارویی در سطح میکروارگانیسمها یک تهدید جهانی بهداشت است.

علائم مقاومت آنتی بیوتیکی چیست؟
وقتی باکتریها یا دیگر میکروارگانیسمها نسبت به دارویی که قبلاً مؤثر بوده، مقاوم میشوند، علائم بالینی عفونت ممکن است تغییر نکند ولی یک شاخص کلیدی ظهور مییابد: درمان با آنتیبیوتیک معمول یا پیشبینیشده کار نمیکند یا به کندی کار میکند و دوره بیماری طولانیتر میشود. به عبارت دیگر، اگر بعد از تجویز داروی مناسب و کامل، هنوز وضعیت بیمار بهبود نیافته یا حتی بدتر شده، احتمال دارد عامل مقاومتآمیز دخیل باشد. در واقع یکی از هشدارها این است که روند درمان کندتر و دشوارتر میشود. باید تأکید شود که علائم بالینی خودِ مقاومت نیستند؛ به این معنا که نمیتوان فقط بر اساس علامت گفت «بله، این مقاوم شده». بلکه هشدار مهم عبارت است از «عدم بهبود یا بدتر شدن حال بیمار طی درمان مناسب» یعنی ممکن است شما عفونتی داشته باشید که به آنتیبیوتیک استاندارد پاسخ نمیدهد.
بنابراین، مهم است که اگر پس از مدت مناسبی از مصرف داروی تجویزی، بهبود حاصل نشود، یا علائم جدیدی ظاهر شود، پزشک را مطلع کرده و آزمایشهای حساسیت میکروبی را انجام شود.
از دید عمومی نیز، سازمان World Health Organization (WHO) تأکید کرده که وقتی میکروبها به داروها پاسخ ندهند، عواقب میتواند جدی باشد: طولانی شدن درمان، افزایش خطر مرگ، و عوارض جانبی بیشتر درمانهای پیچیدهتر.
در نتیجه علائم مقاومت را میتوان اینطور خلاصه کرد: «عفونتی که معمولاً با درمان قابل کنترل است، با درمان درست بهبود نمییابد؛ یا نیاز به داروی دوم یا سوم پیدا میکند؛ یا علائم عفونت شدیدتر میشود؛ یا عفونت به بخش جدیدی گسترش مییابد».
درک این موضوع برای بیماران، صاحبان و یا خانوادهشان و کادر درمان مهم است چون شناسایی زودهنگام مقاومت دارویی میتواند به تغییر سریع درمان و جلوگیری از پیامدهای شدیدتر کمک کند. توصیه میشود: اگر دارویی تجویز شده را طبق دستور کامل انجام دادید (دوز و مدت)، اما وضعیتتان بهتر نشد یا بدتر شد، حتماً به پزشک مراجعه کنید و احتمال عفونت مقاوم را بررسی نمایید.
بطور خلاصه می توان گفت که مقاومت آنتیبیوتیکی فقط به معنی «دارو اثر ندارد» نیست، بلکه شامل وضعیتهایی است که درمانِ معمولی کافی نیست، روند بهبود کندتر است، و ممکن است نیاز به اقدامات تخصصیتر باشد. آگاهی از این موضوع میتواند کمک بزرگی در مدیریت سریعتر عفونتها باشد.

کاربرد مواد ضد میکروبی در حیوانات
عوامل ضد میکروبی در حیوانات به دلایل مختلفی استفاده میشوند که ممکن است شامل موارد زیر باشند (مطابق با مقررات اتحادیه اروپا، شماره EU 2019/6):
-
درمان عفونتها (درمان ضد میکروبی)
تجویز عوامل ضد میکروبی برای درمان حیواناتی که بر اساس شواهد بالینی دچار بیماری عفونی شدهاند.
-
کنترل گسترش عفونتها (متافیلاکسی)
تجویز یک داروی درمانی به گروهی از حیوانات پس از آنکه در بخشی از آن گروه بیماری عفونی بهصورت بالینی تشخیص داده شده است؛ با هدف درمان حیوانات بیمار و جلوگیری از گسترش بیماری به حیوانات در تماس نزدیک یا در معرض خطر، که ممکن است پیش از بروز علائم بالینی، بهصورت تحتبالینی آلوده شده باشند یعنی هنوز نشانههای بیماری را نشان ندادهاند.
-
پیشگیری از عفونتها (پروفیلاکسی)
تجویز یک داروی درمانی به یک حیوان یا گروهی از حیوانات پیش از بروز علائم بالینی بیماری، بهمنظور پیشگیری از وقوع بیماری یا عفونت.
بر اساس قوانین اروپایی در زمینهی داروهای دامپزشکی، استفاده از عوامل ضد میکروبی برای پروفیلاکسی تنها در موارد استثنایی مجاز است — آنهم در یک حیوان منفرد یا تعداد محدودی از حیوانات، زمانی که خطر بروز عفونت بسیار بالا باشد و پیامدهای آن احتمالاً شدید خواهد بود.
همچنین، محصولات دارویی ضد میکروبی باید برای متافیلاکسی تنها زمانی استفاده شوند که خطر گسترش عفونت یا بیماری عفونی در گروه حیوانات بالا باشد و هیچ جایگزین مناسب دیگری در دسترس نباشد.

پیامدهای مقاومت ضدمیکروبی در دامپزشکی
حیوانات میتوانند مخازنِ میکروبهای مقاوم باشند؛ این عامل هم سلامت حیوان را تهدید میکند (کاهش رفاه و افزایش مرگومیر در گله) و هم از طریق زنجیره غذا و تماس نزدیک انسانها، خطر انتقال را بالا میبرد. مصرف آنتیبیوتیکها برای رشد یا پیشگیری در مرغداری و دامداری ها، در بسیاری از کشورها باعث ظهور و پخش ژن های مقاومت شده است؛ از سوی دیگر گزارشهایی نیز از کاهش جهانی مصرف دارو در حیوانات بهدلیل سیاستهای کنترلی وجود دارد که نشان میدهد مداخله مؤثر امکانپذیر است.
کاربرد مواد ضدمیکروبی در انسانها
در انسان، عوامل ضد میکروبی عمدتاً برای اهداف درمانی مورد استفاده قرار میگیرند تا عفونتهای ناشی از باکتریها را درمان کنند.
همچنین میتوان از آنها برای پیشگیری (پروفیلاکسی) استفاده کرد، یعنی برای جلوگیری از بروز عفونتهای باکتریایی، بهویژه در طول فرآیندهای پزشکی (مانند جراحی)، یا برای افرادی که زخم، گزش حیوانات دارند، یا در مورد افرادی که در برابر عفونتها آسیبپذیر هستند و یا بهطور مکرر دچار عفونت میشوند.
پیامدها مقاومت ضدمیکروبی در پزشکی
کاهش گزینههای درمانی برای عفونتهای شایع و حیاتی (مثلاً عفونتهای خون و مجاری ادراری)، افزایش مدت بستری و مرگومیر، و گرانتر و پیچیدهتر شدن پروتکلهای درمانی از عواقب مستقیم است. این وضعیت همچنین ریسک عملهای جراحیِ پیچیده، پیوندها و مراقبتهای ویژه را بالا میبرد چون اکنون پیشگیری و کنترلِ عفونت دشوارتر شده است. تازهترین دادهها نشان میدهند سهم موارد مقاوم در برخی عفونتهای آزمایشگاهی بهطرز نگرانکنندهای افزایش یافته است که نیاز به اقدام جهانی و سرمایهگذاری در تشخیص و داروی جدید را برجسته میکند.